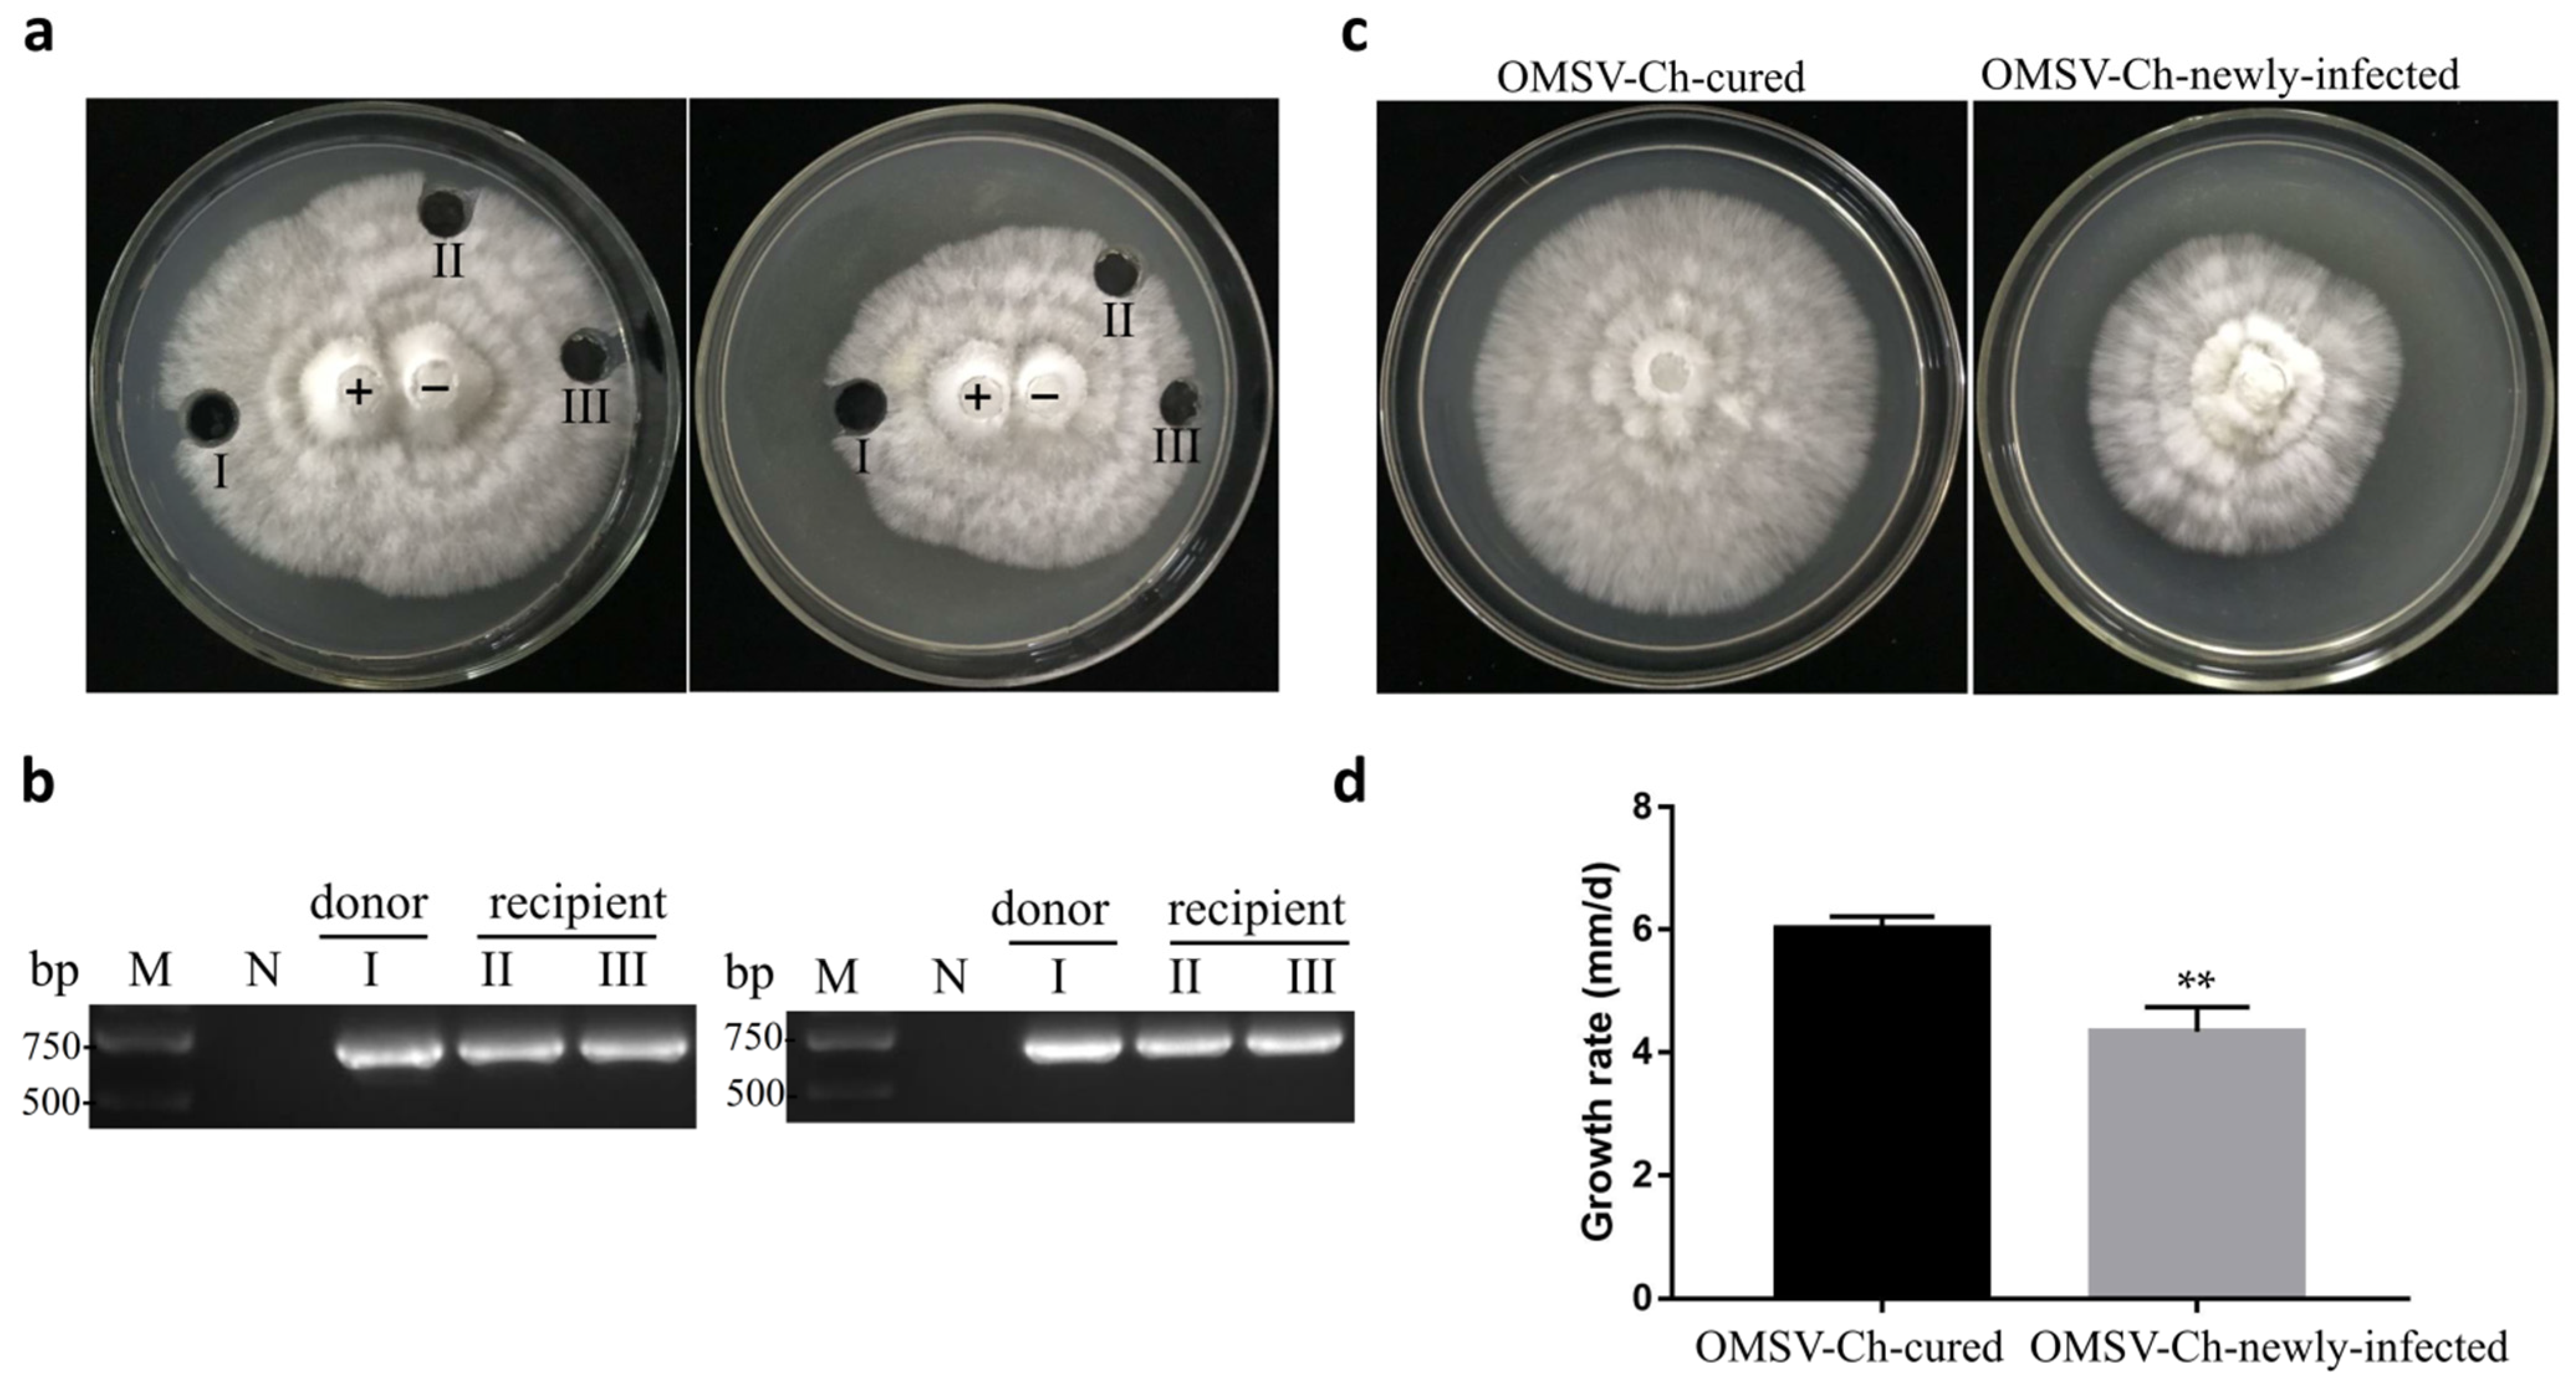

Preliminary Studies on the Effects of Oyster Mushroom Spherical Virus China Strain on the Mycelial Growth and Fruiting Body Yield of the Edible Mushroom Pleurotus ostreatus
Abstract
Simple Summary
Abstract
1. Introduction
2. Materials and Methods
2.1. Mushroom Strain
2.2. RNA Extraction and Reverse Transcription PCR
2.3. Cloning and Sequencing
2.4. Phylogenetic Tree Construction
2.5. Virus Curing
2.6. Determination of Growth Rate
2.7. Cultivation Tests
2.8. Horizontal OMSV-Ch Transmission
3. Results
3.1. Nucleotide Sequence and Genome Organization of the OMSV-Ch Strain
3.2. Phylogenetic Analysis of OMSV-Ch
3.3. Curing of OMSV-Ch from P. ostreatus
3.4. Effects of OMSV-Ch on the Phenotype and Yield of the Fruiting Bodies
3.5. OMSV-Ch Can Horizontally Transfer to a Virus-Cured Strain
4. Discussion
5. Conclusions
Supplementary Materials
Author Contributions
Funding
Institutional Review Board Statement
Informed Consent Statement
Data Availability Statement
Acknowledgments
Conflicts of Interest
References
- Ghabrial, S.A.; Caston, J.R.; Jiang, D.; Nibert, M.L.; Suzuki, N. 50-plus years of fungal viruses. Virology 2015, 479–480, 356–368. [Google Scholar] [CrossRef] [PubMed]
- Kamaruzzaman, M.; He, G.; Wu, M.; Zhang, J.; Yang, L.; Chen, W.; Li, G. A novel partitivirus in the hypovirulent isolate qt5-19 of the plant pathogenic fungus Botrytis cinerea. Viruses 2019, 11, 24. [Google Scholar] [CrossRef]
- Xie, J.; Jiang, D. New insights into mycoviruses and exploration for the biological control of crop fungal diseases. Annu. Rev. Phytopathol. 2014, 52, 45–68. [Google Scholar] [CrossRef]
- Fuke, K.; Takeshita, K.; Aoki, N.; Fukuhara, T.; Egusa, M.; Kodama, M.; Moriyama, H. The presence of double-stranded RNAs in Alternaria alternata Japanese pear pathotype is associated with morphological changes. J. Gen. Plant Pathol. 2011, 77, 248–252. [Google Scholar] [CrossRef]
- Shapira, R.; Choi, G.H.; Nuss, D.L. Virus-like genetic organization and expression strategy for a double-stranded RNA genetic element associated with biological control of chestnut blight. EMBO J. 1991, 10, 731–739. [Google Scholar] [CrossRef] [PubMed]
- Linnakoski, R.; Sutela, S.; Coetzee, M.P.A.; Duong, T.A.; Pavlov, I.N.; Litovka, Y.A.; Hantula, J.; Wingfield, B.D.; Vainio, E.J. Armillaria root rot fungi host single-stranded RNA viruses. Sci. Rep. 2021, 11, 7336. [Google Scholar] [CrossRef] [PubMed]
- Guo, M.; Shen, G.; Wang, J.; Liu, M.; Bian, Y.; Xu, Z. Mycoviral diversity and characteristics of a negative-stranded RNA virus LeNSRV1 in the edible mushroom Lentinula edodes. Virology 2021, 555, 89–101. [Google Scholar] [CrossRef]
- Lin, Y.H.; Fujita, M.; Chiba, S.; Hyodo, K.; Andika, I.B.; Suzuki, N.; Kondo, H. Two novel fungal negative-strand RNA viruses related to mymonaviruses and phenuiviruses in the shiitake mushroom (Lentinula edodes). Virology 2019, 533, 125–136. [Google Scholar] [CrossRef]
- Komatsu, A.; Kondo, H.; Sato, M.; Kurahashi, A.; Nishibori, K.; Suzuki, N.; Fujimori, F.J.M. Isolation and characterization of a novel mycovirus infecting an edible mushroom, Grifola frondosa. Mycoscience 2019, 60, 211–220. [Google Scholar] [CrossRef]
- Sahin, E.; Akata, I. Viruses infecting macrofungi. Virusdisease 2018, 29, 1–18. [Google Scholar] [CrossRef]
- Qiu, L.; Li, Y.; Liu, Y.; Gao, Y.; Qi, Y.; Shen, J. Particle and naked RNA mycoviruses in industrially cultivated mushroom Pleurotus ostreatus in China. Fungal Biol. 2010, 114, 507–513. [Google Scholar] [CrossRef] [PubMed]
- Magae, Y.; Sunagawa, M. Characterization of a mycovirus associated with the brown discoloration of edible mushroom, Flammulina velutipes. Virol. J. 2010, 7, 342. [Google Scholar] [CrossRef][Green Version]
- Ro, H.S.; Kang, E.J.; Yu, J.S.; Lee, T.S.; Lee, C.W.; Lee, H.S. Isolation and characterization of a novel mycovirus, PeSV, in Pleurotus eryngii and the development of a diagnostic system for it. Biotechnol. Lett. 2007, 29, 129–135. [Google Scholar] [CrossRef] [PubMed]
- Ro, H.S.; Lee, N.J.; Lee, C.W.; Lee, H.S. Isolation of a novel mycovirus OMIV in Pleurotus ostreatus and its detection using a triple antibody sandwich-ELISA. J. Virol. Methods 2006, 138, 24–29. [Google Scholar] [CrossRef]
- Revill, P.A.; Davidson, A.D.; Wright, P.J. The nucleotide sequence and genome organization of mushroom bacilliform virus: A single-stranded RNA virus of Agaricus bisporus (Lange) imbach. Virology 1994, 202, 904–911. [Google Scholar] [CrossRef] [PubMed]
- Chen, K.; Liang, P.; Yu, M.; Chang, S.T. A new double-stranded RNA virus from Volvariella volvacea. Mycologia 1988, 80, 849–853. [Google Scholar] [CrossRef]
- Barroso, G.; Labarère, J. Evidence for viral and naked double-stranded RNAs in the basidiomycete Agrocybe aegerita. Curr. Genet. 1990, 18, 231–237. [Google Scholar] [CrossRef]
- Huttinga, H.; Wichers, H.J.; Zaayen, D.V. Filamentous and polyhedral virus-like particles in Boletus edulis. Neth. J. Plant Pathol. 1975, 81, 102–106. [Google Scholar] [CrossRef]
- Bellettini, M.B.; Bellettini, S.; Fiorda, F.A.; Pedro, A.C.; Bach, F.; Fabela-Moron, M.F.; Hoffmann-Ribani, R. Diseases and pests noxious to Pleurotus spp. mushroom crops. Rev. Argent. Microbiol. 2018, 50, 216–226. [Google Scholar] [CrossRef]
- Kim, S.W.; Kim, M.G.; Kim, J.; Lee, H.S.; Ro, H.S. Detection of the mycovirus OMSV in the edible mushroom, Pleurotus ostreatus, using an SPR biosensor chip. J. Virol. Methods 2008, 148, 120–124. [Google Scholar] [CrossRef]
- Hoa, H.T.; Wang, C.L.; Wang, C.H. The effects of different substrates on the growth, yield, and nutritional composition of two oyster mushrooms (Pleurotus ostreatus and Pleurotus cystidiosus). Mycobiology 2015, 43, 423–434. [Google Scholar] [CrossRef] [PubMed]
- Chorváthová, V.; Bobek, P.; Ginter, E.; Klvanová, J. Effect of the oyster fungus on glycaemia and cholesterolaemia in rats with insulin-dependent diabetes. Physiol. Res. 1993, 42, 175–179. [Google Scholar] [PubMed]
- Song, H.Y.; Choi, H.J.; Jeong, H.; Choi, D.; Kim, D.H.; Kim, J.M. Viral effects of a dsRNA mycovirus (PoV-ASI2792) on the vegetative growth of the edible mushroom Pleurotus ostreatus. Mycobiology 2016, 44, 283–290. [Google Scholar] [CrossRef] [PubMed]
- Kim, Y.J.; Kim, J.Y.; Kim, J.H.; Yoon, S.M.; Yoo, Y.B.; Yie, S.W. The identification of a novel Pleurotus ostreatus dsRNA virus and determination of the distribution of viruses in mushroom spores. J. Microbiol. 2008, 46, 95–99. [Google Scholar] [CrossRef]
- Lim, W.S.; Jeong, J.H.; Jeong, R.D.; Yoo, Y.B.; Yie, S.W.; Kim, K.H. Complete nucleotide sequence and genome organization of a dsRNA partitivirus infecting Pleurotus ostreatus. Virus Res. 2005, 108, 111–119. [Google Scholar] [CrossRef]
- Yu, H.J.; Lim, D.; Lee, H.-S. Characterization of a novel single-stranded RNA mycovirus in Pleurotus ostreatus. Virology 2003, 314, 9–15. [Google Scholar] [CrossRef]
- Shi, Y.C.; Xie, A.T.; Wang, X.L.; Wang, S.J.; Liu, X.D.; Zhou, T. Detection of oyster mushroom spherical virus in Beijing and its controlling measures. China Plant Prot. 2016, 36, 9–11. (In Chinese) [Google Scholar]
- Fernández-Fueyo, E.; Castanera, R.; Ruiz-Dueñas, F.J.; López-Lucendo, M.F.; Ramírez, L.; Pisabarro, A.G.; Martínez, A.T. Ligninolytic peroxidase gene expression by Pleurotus ostreatus: Differential regulation in lignocellulose medium and effect of temperature and pH. Fungal Genet. Biol. 2014, 72, 150–161. [Google Scholar] [CrossRef]
- Bruenn, J.A. A closely related group of RNA-dependent RNA polymerases from double-stranded RNA viruses. Nucleic Acids Res. 1993, 21, 5667–5669. [Google Scholar] [CrossRef]
- Charles, J.; Tangudu, C.S.; Hurt, S.L.; Tumescheit, C.; Firth, A.E.; Garcia-Rejon, J.E.; Machain-Williams, C.; Blitvich, B.J. Discovery of a novel Tymoviridae-like virus in mosquitoes from Mexico. Arch. Virol. 2019, 164, 649–652. [Google Scholar] [CrossRef]
- Wang, L.; Lv, X.; Zhai, Y.; Fu, S.; Wang, D.; Rayner, S.; Tang, Q.; Liang, G. Genomic characterization of a novel virus of the family Tymoviridae isolated from mosquitoes. PLoS ONE 2012, 7, e39845. [Google Scholar] [CrossRef] [PubMed]
- Martelli, G.P.; Sabanadzovic, S.; Abou-Ghanem Sabanadzovic, N.; Edwards, M.C.; Dreher, T. The family Tymoviridae. Arch. Virol. 2002, 147, 1837–1846. [Google Scholar] [CrossRef] [PubMed]
- Martelli, G.P.; Sabanadzovic, S.; Abou Ghanem-Sabanadzovic, N.; Saldarelli, P. Maculavirus, a new genus of plant viruses. Arch. Virol. 2002, 147, 1847–1853. [Google Scholar] [CrossRef]
- Morch, M.D.; Boyer, J.C.; Haenni, A.L. Overlapping open reading frames revealed by complete nucleotide sequencing of turnip yellow mosaic virus genomic RNA. Nucleic Acids Res. 1988, 16, 6157–6173. [Google Scholar] [CrossRef] [PubMed]
- Izadpanah, K.; Zhang, Y.P.; Daubert, S.; Masumi, M.; Rowhani, A. Sequence of the coat protein gene of Bermuda grass etched-line virus, and of the adjacent 'marafibox' motif. Virus Genes 2002, 24, 131–134. [Google Scholar] [CrossRef]
- Ding, S.W.; Howe, J.; Keese, P.; Mackenzie, A.; Meek, D.; Osorio-Keese, M.; Skotnicki, M.; Srifah, P.; Torronen, M.; Gibbs, A. The tymobox, a sequence shared by most tymoviruses: Its use in molecular studies of tymoviruses. Nucleic Acids Res. 1990, 18, 1181–1187. [Google Scholar] [CrossRef]
- Nibert, M.L.; Ghabrial, S.A.; Maiss, E.; Lesker, T.; Vainio, E.J.; Jiang, D.; Suzuki, N. Taxonomic reorganization of family Partitiviridae and other recent progress in partitivirus research. Virus Res. 2014, 188, 128–141. [Google Scholar] [CrossRef]
- Roossinck, M.J. Lifestyles of plant viruses. Philos. Trans. R. Soc. Lond B Biol. Sci. 2010, 365, 1899–1905. [Google Scholar] [CrossRef]
- Kim, J.M.; Song, H.Y.; Choi, H.J.; Yun, S.H.; So, K.K.; Ko, H.K.; Kim, D.H. Changes in the mycovirus (LeV) titer and viral effect on the vegetative growth of the edible mushroom Lentinula edodes. Virus Res. 2015, 197, 8–12. [Google Scholar] [CrossRef]
- Kim, J.M.; Yun, S.H.; Park, S.M.; Ko, H.G.; Kim, D.H. Occurrence of dsRNA Mycovirus (LeV-FMRI0339) in the Edible Mushroom Lentinula edodes and Meiotic Stability of LeV-FMRI0339 among Monokaryotic Progeny. Plant Pathol. J. 2013, 29, 460–464. [Google Scholar] [CrossRef][Green Version]
- Kwon, Y.C.; Jeong, D.W.; Gim, S.I.; Ro, H.S.; Lee, H.S. Curing viruses in Pleurotus ostreatus by growth on a limited nutrient medium containing cAMP and rifamycin. J. Virol. Methods 2012, 185, 156–159. [Google Scholar] [CrossRef] [PubMed]
- Herrero, N.; Zabalgogeazcoa, I. Mycoviruses infecting the endophytic and entomopathogenic fungus Tolypocladium cylindrosporum. Virus Res. 2011, 160, 409–413. [Google Scholar] [CrossRef] [PubMed]
- Romo, M.; Leuchtmann, A.; García, B.; Zabalgogeazcoa, I. A totivirus infecting the mutualistic fungal endophyte Epichloë festucae. Virus Res. 2007, 124, 38–43. [Google Scholar] [CrossRef] [PubMed]
- Van Diepeningen, A.D.; Debets, A.J.; Hoekstra, R.F. Dynamics of dsRNA mycoviruses in black Aspergillus populations. Fungal Genet. Biol. 2006, 43, 446–452. [Google Scholar] [CrossRef] [PubMed]

| Strain | Period from Inoculation to Harvest (Day) | 1st Flush Yield (g/bag) | 2nd Flush Yield (g/bag) |
|---|---|---|---|
| OMSV-Ch-infected | 35.36 ± 2.54 | 171.72 ± 11.45 | 121.10 ± 13.25 |
| OMSV-Ch-cured | 29.00 ± 1.67 *** | 216.48 ± 14.92 *** | 172.96 ± 9.18 *** |
Publisher’s Note: MDPI stays neutral with regard to jurisdictional claims in published maps and institutional affiliations. |
© 2022 by the authors. Licensee MDPI, Basel, Switzerland. This article is an open access article distributed under the terms and conditions of the Creative Commons Attribution (CC BY) license (https://creativecommons.org/licenses/by/4.0/).
Share and Cite
Hu, H.-J.; Wang, J.-R.; Cheng, X.-H.; Liu, Y.; Zhang, X.-Y. Preliminary Studies on the Effects of Oyster Mushroom Spherical Virus China Strain on the Mycelial Growth and Fruiting Body Yield of the Edible Mushroom Pleurotus ostreatus. Biology 2022, 11, 574. https://doi.org/10.3390/biology11040574
Hu H-J, Wang J-R, Cheng X-H, Liu Y, Zhang X-Y. Preliminary Studies on the Effects of Oyster Mushroom Spherical Virus China Strain on the Mycelial Growth and Fruiting Body Yield of the Edible Mushroom Pleurotus ostreatus. Biology. 2022; 11(4):574. https://doi.org/10.3390/biology11040574
Chicago/Turabian StyleHu, Hai-Jing, Jian-Rui Wang, Xian-Hao Cheng, Yu Liu, and Xiao-Yan Zhang. 2022. "Preliminary Studies on the Effects of Oyster Mushroom Spherical Virus China Strain on the Mycelial Growth and Fruiting Body Yield of the Edible Mushroom Pleurotus ostreatus" Biology 11, no. 4: 574. https://doi.org/10.3390/biology11040574
APA StyleHu, H.-J., Wang, J.-R., Cheng, X.-H., Liu, Y., & Zhang, X.-Y. (2022). Preliminary Studies on the Effects of Oyster Mushroom Spherical Virus China Strain on the Mycelial Growth and Fruiting Body Yield of the Edible Mushroom Pleurotus ostreatus. Biology, 11(4), 574. https://doi.org/10.3390/biology11040574

